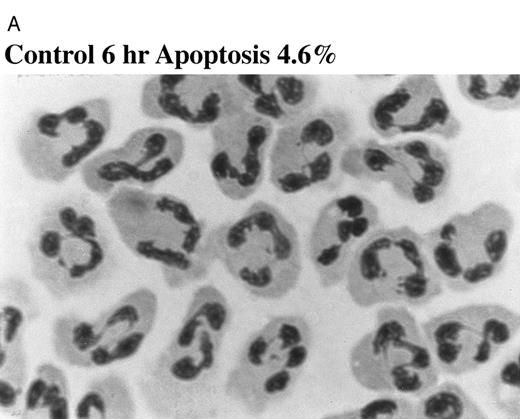
Fig. 2. Effect of TNF-α on neutrophil morphology and propidium iodide (PI) staining. Human neutrophils were incubated in the presence (A and B, righthand panels) or absence (A and B, lefthand panels) of 12.5 ng/mL TNF-α as detailed in the legend to Fig 1. (A) Cytocentrifuge preparations were prepared after 6 hours and cells fixed, stained, and examined under 100× objective oil immersion light microscopy. Cells with classical apoptotic morphology are arrowed. (B) After 6 or 20 hours in culture cells were resuspended in ice-cold 70% ethanol, washed in PBS, and incubated with PI in the presence of RNAase before analysis using an EPICS Profile II. Mean fluorescence values are shown for a minimum of 5,000 cells for each condition and are representative of six to nine determinations in three separate experiments.

Abstract
Granulocyte apoptosis is an important mechanism underlying the removal of redundant neutrophils from an inflammatory focus. The ability of many proinflammatory agents to impede this event suggests that such agents act not only in a priming or secretagogue capacity but also increase neutrophil longevity by delaying apoptosis. We have examined whether this hypothesis holds true for all neutrophil priming agents, in particular tumor necrosis factor-α (TNF-α), which has been variably reported to either induce, delay, or have no effect on neutrophil apoptosis. After 20 hours coincubation TNF-α inhibited neutrophil apoptosis; however, more detailed analysis demonstrated its ability to promote apoptosis in a subpopulation of cells at earlier (2 to 8 hours) times. Formyl-Met-Leu-Phe, platelet-activating factor, inositol hexakisphosphate, lipopolysaccharide, leukotriene B4 , and granulocyte-macrophage colony-stimulating factor all inhibited apoptosis at 6 and 20 hours. The early proapoptotic effect of TNF-α was concentration-dependent (EC50 2.8 ng/mL), abolished by TNF-α neutralizing antibody, and was not associated with any change in cell viability or recovery. Of relevance to the inflamed site, the ability of TNF-α to accelerate apoptosis was lost if neutrophils were primed with 1 μmol/L PAF or aged for 6 hours before TNF-α addition. The TNFR55-selective TNF-α mutants (E146K, R32W-S86T) induced neutrophil apoptosis but with a potency 14-fold lower than wild-type TNF-α. Although the TNFR75-selective mutant (D143F ) did not induce apoptosis, blocking antibodies to both receptor subtypes abolished TNF-α–stimulated apoptosis. Hence, TNF-α has the unique ability to induce apoptosis in human neutrophils via a mechanism where TNFR75 facilitates the dominant TNFR55 death effect. This may be an important mechanism controlling neutrophil longevity and clearance in vivo.
NEUTROPHIL APOPTOSIS, which results in the recognition and uptake of these cells by macrophages, has been proposed as an important mechanism for the removal of neutrophils from sites of inflammation.1-6 Experimental data obtained using human peripheral blood neutrophils show that these cells undergo constitutive apoptosis when aged in vitro and that this process is associated with maintenance of membrane integrity, hyporesponsiveness to external secretagogue signals, and the capacity to be phagocytosed intact by macrophages and certain other cells with phagocytic potential.1-5,7 The speed and capacity of the macrophage phagocytic response toward apoptotic neutrophils, together with the observation that engulfment does not excite a proinflammatory macrophage response,8 predicts that this process plays an important role in the safe disposal of intact but effete neutrophils from an inflamed focus. This view is supported by the recent demonstration of this process occurring in vivo; for example, in endotoxin-induced experimental lung injury,9 the neonatal respiratory distress syndrome,10 and experimental glomerulonephritis.11
Although the mechanisms involved in regulating neutrophil survival and death are poorly understood, there is now considerable evidence to suggest that this process is not immutable because the rate at which these cells undergo apoptosis, at least in vitro, can be altered. For example, the colony-stimulating factors granulocyte colony-stimulating factor (G-CSF ) and granulocyte-macrophage-CSF (GM-CSF ), lipopolysaccharide (LPS), and hypoxia all increase the survival of these cells by delaying apoptosis12-17 implying that certain agents may upregulate neutrophil function both by priming for enhanced functional responsiveness to secretagogue agonists and by delaying apoptosis which prolongs their functional life span.16
One cytokine of particular interest in this paradigm is tumour necrosis factor-α (TNF-α). This agent is a powerful priming agonist in neutrophils yet has the capacity along with other low-affinity nerve growth factor (NGF ) receptor ligands to induce apoptosis in a variety of cells, including T lymphocytes18 and HL-60 cells.19 In contrast, a number of reports have indicated that TNF-α has the opposite effect, ie, delays apoptosis, in human monocytes, neutrophils, and B104 lymphoma cells.20-22 Interest in this area has been heightened by the recent finding of Zheng et al,18 who showed that the induction of apoptosis in CD8+ T cells by TNF-α is mediated via the TNFR75 rather than the classical death domain–containing TNFR55.23
The aim of this study was to undertake a detailed characterization of the effects of TNF-α on neutrophil apoptosis in vitro. We show that while prolonged incubation (>12 hours) of human neutrophils with TNF-α indeed causes a decrease in the extent of apoptosis, TNF-α can induce apoptosis in a proportion of cells at earlier times (<8 hours). The early proapoptotic effect of TNF-α (1) appears to be unique to this cytokine because it is not observed with other priming or secretagogue agonists, (2) is abolished by initial priming of the cells with platelet-activating factor (PAF ), an effect that is not secondary to a change in TNFR55 or TNFR75 expression, and (3) appears critically dependent on TNF-α interaction with both TNF receptor subtypes as determined by blocking TNF-α receptor antibodies and TNF-α mutants which display selective binding to the two TNF-α receptors.24-26
Time course for the effect of TNF-α on apoptosis in human neutrophils. Human neutrophils (5 × 106/mL) were incubated in MDM containing 10% autologous serum alone (▧), or in the presence of 25 ng/mL TNF-α (▪) or 50 U/mL GM-CSF (□) at 37°C. At the time periods indicated, the cells were resuspended and cytocentrifuge preparations made. These were fixed, stained, and percent apoptosis assessed morphologically. (A) Represents the effects of TNF-α after 3, 6, 12, and 20 hours of incubation with the results from a separate series of experiments over a 1- to 8-hour time course shown in (B). The comparative effects of GM-CSF on neutrophil apoptosis at 6 and 20 hours are shown in (C). All values represent mean ± SEM of n = 3 separate experiments, each performed in triplicate (*P < .05 compared with time-matched controls). Where not shown, SEM values are less than 2% of means.
Time course for the effect of TNF-α on apoptosis in human neutrophils. Human neutrophils (5 × 106/mL) were incubated in MDM containing 10% autologous serum alone (▧), or in the presence of 25 ng/mL TNF-α (▪) or 50 U/mL GM-CSF (□) at 37°C. At the time periods indicated, the cells were resuspended and cytocentrifuge preparations made. These were fixed, stained, and percent apoptosis assessed morphologically. (A) Represents the effects of TNF-α after 3, 6, 12, and 20 hours of incubation with the results from a separate series of experiments over a 1- to 8-hour time course shown in (B). The comparative effects of GM-CSF on neutrophil apoptosis at 6 and 20 hours are shown in (C). All values represent mean ± SEM of n = 3 separate experiments, each performed in triplicate (*P < .05 compared with time-matched controls). Where not shown, SEM values are less than 2% of means.
Effect of TNF-α on neutrophil morphology and propidium iodide (PI) staining. Human neutrophils were incubated in the presence (A and B, righthand panels) or absence (A and B, lefthand panels) of 12.5 ng/mL TNF-α as detailed in the legend to Fig 1. (A) Cytocentrifuge preparations were prepared after 6 hours and cells fixed, stained, and examined under 100× objective oil immersion light microscopy. Cells with classical apoptotic morphology are arrowed. (B) After 6 or 20 hours in culture cells were resuspended in ice-cold 70% ethanol, washed in PBS, and incubated with PI in the presence of RNAase before analysis using an EPICS Profile II. Mean fluorescence values are shown for a minimum of 5,000 cells for each condition and are representative of six to nine determinations in three separate experiments.
Effect of TNF-α on neutrophil morphology and propidium iodide (PI) staining. Human neutrophils were incubated in the presence (A and B, righthand panels) or absence (A and B, lefthand panels) of 12.5 ng/mL TNF-α as detailed in the legend to Fig 1. (A) Cytocentrifuge preparations were prepared after 6 hours and cells fixed, stained, and examined under 100× objective oil immersion light microscopy. Cells with classical apoptotic morphology are arrowed. (B) After 6 or 20 hours in culture cells were resuspended in ice-cold 70% ethanol, washed in PBS, and incubated with PI in the presence of RNAase before analysis using an EPICS Profile II. Mean fluorescence values are shown for a minimum of 5,000 cells for each condition and are representative of six to nine determinations in three separate experiments.
MATERIALS AND METHODS
Neutrophil preparation and culture.Human neutrophils were purified from the peripheral blood of healthy human volunteers exactly as detailed previously.27 Cell purity was assessed using cytocentrifuge preparations fixed in methanol and stained with May/Grünwald/Giemsa (Merck Ltd, Lutterworth, Leicestershire, UK) and was routinely greater than 95% neutrophils with less than 0.1% mononuclear cell contamination. Viability was assessed by the ability of the cells to exclude trypan blue and was consistently greater than 99% under all experimental conditions reported. Freshly harvested neutrophils were routinely suspended at a density of 5 × 106/mL in Iscove's modified Dulbecco's medium (MDM) supplemented with 10% autologous serum and 50 U/mL penicillin and streptomycin and cultured at 6.75 × 105 cells/150 μL in flat-bottomed 96-well Falcon flexiwell plates (Becton Dickinson, Oxford, UK) in a humidified 5% CO2 atmosphere at 37°C.
To examine the effects of neutrophil priming agents, freshly isolated cells were cultured in the presence or absence of (final concentrations) formyl-Met-Leu-Phe (fMLP) (1 nmol/L), PAF (1 μmol/L), inositol hexakisphosphate (InsP6 ; 100 μmol/L), LPS (100 ng/mL), leukotriene B4 (LTB4 ; 100 nmol/L), GM-CSF (50 U/mL), or TNF-α (0.005 to 100 ng/mL). After incubation for the time periods indicated (1 to 20 hours), apoptosis was quantified as detailed below.
Morphological assessment of PMN apoptosis.After gentle resuspension, neutrophils were harvested, cytocentrifuged, and the resulting slide preparations fixed and stained as described above with cell viability (trypan blue exclusion) and recovery assessed in parallel. Cell morphology was examined under oil immersion light microscopy, and apoptotic neutrophils defined as cells containing darkly stained pyknotic nuclei.1 For each condition examined, slides were prepared from triplicate incubations and a total of at least 500 neutrophils covering five high-power fields counted with the observer blinded to the assay conditions.
Chromatin fragmentation assay and propidium iodide staining.For preparation of genomic DNA, neutrophils were incubated in the presence or absence of 1 to 100 ng/mL TNF-α or 10 and 100 ng/mL E146K and D143F for 3 hours, pelleted, and resuspended in 2 mL 150 mmol/L sodium acetate, 5 mmol/L EDTA (pH 7). After addition of a further 2 mL of sodium acetate/EDTA containing 0.2 mg/mL proteinase K and 1% sodium dodecyl sulphate (SDS) the samples were incubated overnight at 55°C. Fresh proteinase K (0.1 mg/mL) was added and samples were incubated for a further 1 hour at 55°C before cooling to room temperature. Thereafter, 4 mL of phenol was added, samples mixed for 30 minutes, centrifuged (5,000g, 10 minutes), and the DNA phase extracted in an equal volume of phenol/chloroform. After centrifugation the upper phase was removed and extracted in an equal volume of chloroform and the DNA precipitated with 2 vol of absolute ethanol. The precipitate was washed in 75% ethanol followed by absolute ethanol. After evaporation of the ethanol at room temperature the pellet was dissolved in 250 mL TE buffer (10 mmol/L Tris/HCl, 1 mmol/L EDTA, pH 8) and quantified by reading the absorbance at 260 nm (DU-50 Beckman spectrophotometer, High Wycombe, UK). Loading buffer (0.25% bromophenol blue, 0.25% xylene cyanol FF, 30% glycerol in water) containing RNAase A (1:100 dilution of 10 mg/mL) was added and 3 to 10 μg DNA electrophoresed in a 1.2% agarose gel at 40 V in 40 mmol/L Tris-acetate, 1 mmol/L EDTA.
Effect of neutrophil cell concentration on the early proapoptotic effect of TNF-α. Human neutrophils were incubated at a cell concentration of 2.5 to 15 × 106/mL in the presence (▪) or absence (▧) of TNF-α (12.5 ng/mL) for 6 hours at 37°C. Cytocentrifuge slides were then prepared for morphological assessment of apoptosis. Data represent the mean ± SEM of six observations in two separate experiments.
Effect of neutrophil cell concentration on the early proapoptotic effect of TNF-α. Human neutrophils were incubated at a cell concentration of 2.5 to 15 × 106/mL in the presence (▪) or absence (▧) of TNF-α (12.5 ng/mL) for 6 hours at 37°C. Cytocentrifuge slides were then prepared for morphological assessment of apoptosis. Data represent the mean ± SEM of six observations in two separate experiments.
Propidium iodide (PI) staining was assessed according to Nicoletti et al,28 with the following modifications: 0.4 × 106 cells were suspended in 100 μL ice-cold 70% ethanol for 10 minutes, washed (×3) in phosphate-buffered saline (PBS) (4°C), and resuspended in 30 μL PBS and 30 μL RNAase (100 μg/mL). After gentle mixing 60 μL of propidium iodide (100 μg/mL in PBS) was added; the cells were incubated in the dark at room temperature for 15 minutes and after washing in PBS stored at 4°C before analysis using an EPICS Profile II (Coulter Electronics, Luton, UK). Mean fluorescence values were determined from a minimum of 5,000 cells within an analysis region corresponding to nonfragmented neutrophils.
Measurement of superoxide anion generation.The release of superoxide anions was determined by means of the superoxide dismutase-inhibitable reduction of cytochrome C. Neutrophils (106 in 90 μL PBS containing CaCl2 and MgCl2 ) were placed in 2-mL polypropylene tubes containing 10 μL TNF-α to give a final concentration of 0.05 to 50 ng/mL, or PBS (control). Each reaction was performed in quadruplicate. Samples were incubated in the presence or absence of TNF-α for 30 minutes at 37°C in a shaking water bath before the addition of 750 μL cytochrome C (final concentration 1.2 mg/mL) to all samples and 50 μL of superoxide dismutase (20 μg/mL in PBS) to one sample in each quadruplicate. After a final 10-minute incubation with PBS or fMLP (100 nmol/L), samples were placed on ice and the optical density of the supernatants determined using a scanning spectrophotometer (Pye-Unicam 8700; Unicam Ltd, Cambridge, UK) measuring peak height at 550 nm with the paired dismutase-containing supernatants as reference. Superoxide release (nmoles/106 cells) was calculated using the extinction coefficient 21 × 103 (mol/L)−1⋅cm−1.
Effects of TNF-α neutralizing antibodies, TNFR55 and TNFR75 blocking antibodies, and TNF-α receptor-selective mutants on basal and TNF-α–stimulated neutrophil apoptosis.Freshly isolated neutrophils were cultured as detailed above in either MDM plus 10% autologous serum alone (control), TNF-α (12.5 ng/mL), mouse IgG1 antihuman TNF-α neutralizing monoclonal antibody (MoAb) (1 μg/mL), or an identical concentration of TNF-α preincubated for 90 minutes at 37°C with the neutralizing antibody. At 6 hours cells were harvested and apoptosis assessed as indicated above. To assess the effect of TNFR55 and TNFR75 blocking antibodies on the ability of TNF-α to modulate the rate of neutrophil apoptosis, cells (5 × 106/mL) were preincubated for 30 minutes at 37°C in MDM containing 10% autologous serum in the presence or absence of 28 μg/mL of mouse IgG1 antihuman TNFR55, rat IgG2b antihuman TNFR75, or isotype-matched IL-2α (p55) receptor MoAb before a 6- or 20- hour incubation with TNF-α (12.5 ng/mL) or buffer and morphological assessment of apoptosis. The saturating concentration of TNFR75 MoAb used was predetermined using a flow cytometry antibody titration assay29 and TNFR55 MoAb used at an identical concentration. In experiments using the TNFR55-selective mutants E146K and R32W-S86T or TNFR75-selective mutant D143F, freshly isolated neutrophils were incubated for 3 or 6 hours in the presence or absence of 0.01 to 100 ng/mL mutein or rhTNF-α as previously detailed30 before morphological quantification of apoptosis or examination of DNA fragmentation.
Effect of Incubation Time and Neutrophil Presence on the Concentration of TNF-α in Supernatants
| Time . | Medium + TNF-α . | Neutrophils + TNF-α . | Neutrophils − TNF-α . |
|---|---|---|---|
| (h) . | (ng/mL) . | (ng/mL) . | (ng/mL) . |
| 0 | 8.87 ± 0.59 | 10.29 ± 1.10 | 0* |
| 3 | 8.33 ± 0.54 | 7.84 ± 0.62 | 0 |
| 6 | 9.18 ± 0.90 | 8.67 ± 0.97 | 0 |
| 12 | 8.96 ± 1.08 | 8.29 ± 0.68 | 0 |
| 20 | 8.69 ± 0.63 | 7.97 ± 0.67 | 0 |
| Time . | Medium + TNF-α . | Neutrophils + TNF-α . | Neutrophils − TNF-α . |
|---|---|---|---|
| (h) . | (ng/mL) . | (ng/mL) . | (ng/mL) . |
| 0 | 8.87 ± 0.59 | 10.29 ± 1.10 | 0* |
| 3 | 8.33 ± 0.54 | 7.84 ± 0.62 | 0 |
| 6 | 9.18 ± 0.90 | 8.67 ± 0.97 | 0 |
| 12 | 8.96 ± 1.08 | 8.29 ± 0.68 | 0 |
| 20 | 8.69 ± 0.63 | 7.97 ± 0.67 | 0 |
Human neutrophils (5 × 106/mL) or medium alone (MDM containing 10% autologous serum) were incubated in the presence (+TNF-α) or absence (−TNF-α) of 12.5 ng/mL TNF-α in flexiwell plates in an humidified 5% CO2 incubator at 37°C for 0 to 20 hours. The supernatants were harvested, frozen, and immunoreactive human TNF-α quantified by ELISA as detailed in the Materials and Methods section. Data represent mean ± SEM of six measurements performed in two separate experiments.
Assay sensitivity 15.6 pg/mL.
Flow cytometric analysis of TNFR55 and TNFR75 expression.Neutrophils were prepared, preincubated for 5 minutes with 1 μmol/L PAF or buffer, and then incubated (6.75 × 105 cells/150 μL MDM containing 10% autologous serum) in flexiwell plates at 37°C for 0 to 6 hours as detailed above. At the appropriate time points the cells were transferred to prechilled U-bottomed flexiwell plates, washed with ice-cold PBS containing 0.2% bovine serum albumin (BSA) and 0.1% sodium azide, and resuspended in 40 μL of a saturating concentration of mouse-antihuman TNFR55, TNFR75, or CD2 MoAb as a negative control (UCHT-1 clone, IgG1 ; SAPU, Carluke, UK). After a 30-minute period on ice the cells were washed twice and incubated with 40 μL fluorescein isothiocyanate (FITC)-conjugated goat-antimouse Ig (Dako, Buckinghamshire, UK; diluted 1 in 40 with PBS/BSA/azide buffer). After washing, samples were analyzed using an EPICS Profile II (Coulter Electronics) and mean fluorescence values from a minimum of 3,000 cells determined.
Concentration-response relationships for TNF-α–induced apoptosis, priming, and direct superoxide anion generation. Human neutrophils were prepared and incubated at 5 × 106/mL with 0 to 100 ng/mL TNF-α for 6 hours for assessment of apoptosis (A) or at 107/mL with 0 to 100 ng/mL TNF-α for 30 minutes before assessment of fMLP-stimulated (100 nmol/L, 10 minutes) (B) or direct superoxide anion generation (10 minutes) (C) using a cytochrome C reduction assay (see Materials and Methods). Values represent mean ± SEM of n = 3 separate experiments, each performed in triplicate. Where not shown, SEM values are less than 2% and fall within the symbols.
Concentration-response relationships for TNF-α–induced apoptosis, priming, and direct superoxide anion generation. Human neutrophils were prepared and incubated at 5 × 106/mL with 0 to 100 ng/mL TNF-α for 6 hours for assessment of apoptosis (A) or at 107/mL with 0 to 100 ng/mL TNF-α for 30 minutes before assessment of fMLP-stimulated (100 nmol/L, 10 minutes) (B) or direct superoxide anion generation (10 minutes) (C) using a cytochrome C reduction assay (see Materials and Methods). Values represent mean ± SEM of n = 3 separate experiments, each performed in triplicate. Where not shown, SEM values are less than 2% and fall within the symbols.
Enzyme-linked immunosorbent assay (ELISA) for TNF-α.Extracellular immunoreactive human TNF-α was quantified using a modification of the double-ligand method as previously described.31 In brief, flat-bottomed 96-well microtiter plates (Immulon 1; Dynatech, Billinghurst, UK) were coated with 100 μL/well mouse-antihuman TNF-α MoAb (2.5 μg/mL in coating buffer; Dynatech) for 3 hours at 37°C and then washed with PBS (pH 7.5), 0.05% Tween-20 (PBS-Tween-20). Microtiter plate nonspecific binding sites were blocked with Dynatech blocking buffer (30 minutes, 37°C). The plates were washed four times (PBS-Tween-20) and cell-free supernatants or TNF-α standards (half-log dilutions of recombinant human [rh]TNF-α, from 7.8 to 500 pg/mL) added in 100-μL aliquots in duplicate and incubated for 16 hours at 4°C. Plates were washed four times (PBS-Tween-20), followed by the addition of 100 μL/well rabbit polyclonal antihuman TNF-α antibody (1 μg/mL in assay diluent; Dynatech) and the plates were incubated for 3 hours at room temperature. The plates were again washed, alkaline phosphatase–conjugated donkey-antirabbit IgG added, and following a further incubation of 3 hours at room temperature, p-nitrophenyl phosphate substrate added in 10% diethylamine (DEA) buffer. Plates were read at 410 nm in an ELISA reader.
Statistics.All values are presented as the mean ± SEM of (n) number of independent experiments. The data were evaluated statistically using the paired or unpaired Students t-test: P values <.05 were considered to be statistically significant.
Materials.Recombinant human TNF-α (10 μg/mL in PBS) and GM-CSF (1 μg/mL in PBS) were purchased from Genzyme (Cambridge, MA) and stored at −70°C before use. Rat-antihuman TNFR75 MoAb and interleukin-2 (IL-2) receptor MoAb were also purchased from Genzyme (Cambridge, MA) and stored at 0.4 to 1 mg/mL in PBS (4°C). The mouse IgG1 antihuman TNF-α neutralizing MoAb and mouse-antihuman TNFR55 and TNFR75 MoAbs were purchased from R & D Systems Europe (Abingdon, Oxon, UK). LTB4 , LPS (Escherichia coli 0111:B4, γ-irradiated), InsP6 (di-potassium salt), fMLP, superoxide dismutase, cytochrome C, Dulbecco's PBS (with or without CaCl2 and MgCl2 ), p-nitrophenyl phosphate, proteinase K, trypan blue, and dextran-500 were all purchased from Sigma Chemical Co (Poole, Dorset, UK). fMLP was dissolved in sterile dimethyl sulfoxide (DMSO) at a stock concentration of 1 mmol/L and stored at −20°C. LTB4 was stored in ethanol at 100 μg/mL at −20°C. C18 PAF was obtained from Calbiochem-Novabiochem UK Ltd (Nottingham, UK) and dissolved in ethanol at a stock concentration of 10 mmol/L. Percoll was obtained from Pharmacia Biotech (St Albans, Hertfordshire, UK). MDM was obtained from Life Technologies (Paisley, Scotland, UK). Alkaline phosphatase–conjugated donkey-antirabbit IgG was purchased from Stratech Scientific Ltd (Luton, Bedfordshire, UK). All other reagents were obtained from Sigma Chemical Co or Merck Ltd and were of the highest purity available.
RESULTS
Effect of TNF-α on the rate of neutrophil apoptosis in vitro.In agreement with previous studies,21 coincubation of human neutrophils with 25 ng/mL TNF-α for 20 hours caused a small but significant inhibition of neutrophil apoptosis (Fig 1A and C). This effect concurs with our previous observations that many other agents that prime or activate human neutrophils either delay (GM-CSF, Fig 1C, C5a, LPS,16 InsP6 ,32 and LTB4 , results not shown), or have no effect on (fMLP and PAF, results not shown), the rate of constitutive apoptosis when assessed at this time point. However, when cytospins were prepared at earlier times (3 to 6 hours) when the basal rate of apoptosis was still low, TNF-α caused a significant increase in the number of apoptotic cells present (Fig 1A). This early proapoptotic effect of TNF-α was rapid (observed in all experiments by 2 hours, Fig 1B), maximal in terms of the ratio of apoptotic to nonapoptotic cells by 6 hours (Fig 1B), and was not observed with any of the other priming/activating agents tested at 6 hours (50 U/mL GM-CSF [Fig 1C], 1 and 100 nmol/L fMLP, 1 μmol/L PAF, 100 μmol/L InsP6 , or 100 μmol/L LTB4 , data not shown). Accurate quantification of the effects of such agents (including TNF-α) beyond 24 hours was not possible because of the development of secondary necrosis at these times.
Loss of the early proapoptotic effect of TNF-α in human neutrophils after delayed addition of TNF-α or pretreatment with PAF. (A) To assess the effect of delayed addition of TNF-α, human neutrophils were incubated at 5 × 106/mL in the absence (▧) or presence of 12.5 ng/mL TNF-α added either at the beginning of the incubation period (▧) or after a delay of 6 hours (▪). The extent of apoptosis was then assessed morphologically at the time points indicated. All data values represent the mean ± SEM of n = 3 separate experiments, each performed in triplicate (*P < .05 compared with time-matched controls). Where not shown, SEM values are less than 2% of means. (B) Human neutrophils (5 × 106/mL) were incubated in MDM containing 10% autologous serum in the presence or absence of PAF (1 μmol/L) for 5 minutes before being placed in 96-well flexiwell plates for a 6-hour incubation with 12.5 ng/mL TNF-α or buffer. Apoptosis was then determined on cytocentrifuge preparations using standard morphological criteria. Values represent mean ± SEM of three separate experiments, each performed in triplicate (*P < .05 compared with controls).
Loss of the early proapoptotic effect of TNF-α in human neutrophils after delayed addition of TNF-α or pretreatment with PAF. (A) To assess the effect of delayed addition of TNF-α, human neutrophils were incubated at 5 × 106/mL in the absence (▧) or presence of 12.5 ng/mL TNF-α added either at the beginning of the incubation period (▧) or after a delay of 6 hours (▪). The extent of apoptosis was then assessed morphologically at the time points indicated. All data values represent the mean ± SEM of n = 3 separate experiments, each performed in triplicate (*P < .05 compared with time-matched controls). Where not shown, SEM values are less than 2% of means. (B) Human neutrophils (5 × 106/mL) were incubated in MDM containing 10% autologous serum in the presence or absence of PAF (1 μmol/L) for 5 minutes before being placed in 96-well flexiwell plates for a 6-hour incubation with 12.5 ng/mL TNF-α or buffer. Apoptosis was then determined on cytocentrifuge preparations using standard morphological criteria. Values represent mean ± SEM of three separate experiments, each performed in triplicate (*P < .05 compared with controls).
The induction of apoptosis by TNF-α at early time points was confirmed by DNA electrophoresis, which showed a typical ladder pattern in TNF-α–treated neutrophils indicative of endonuclease-dependent internucleosomal cleavage (see Fig 8), and by PI staining, which revealed an increase in the percentage of cells with hypodiploid DNA content in TNF-α–treated cells (Fig 2B) (control 6 hours, 4.4% ± 0.3%; 12.5 ng/mL TNF-α 6 hours, 18.2% ± 0.1%; P < .05, n = 3). These latter values exactly match the extent of apoptosis assessed by morphological criteria (Fig 2A) (control 6 hours, 4.6% ± 0.2%; 12.5 ng/mL TNF-α 6 hours, 17.2% ± 1.4%; P < .05, n = 3). The late inhibitory effect of TNF-α on neutrophil apoptosis (20 hours) was also confirmed using this technique (Fig 2B) (percent low PI stained cells: control 20 hours, 55.9% ± 0.3%; 12.5 ng/mL TNF-α 20 hours, 46.9% ± 1.5%; P < .05, n = 3).
Effect of TNF-α receptor selective mutants on human neutrophil apoptosis. (A) Human neutrophils were incubated with 0.01 to 100 ng/mL of wildtype TNF-α (wtTNF-α, ▪), the TNFR55-selective mutants R32WS86T (•) or E146K (♦), and the TNFR75 selective mutant D143F (▴). Apoptosis was assessed morphologically after 3 hours. Data represent mean ± SEM of three experiments each performed in triplicate. (B) Neutrophils were incubated under identical conditions with 0 to 100 ng/mL wild-type TNF-α, 10 to 100 ng/mL E146K, or 10 to 100 ng/mL D143F. Thereafter the cells were pelletted and incubated overnight in sodium acetate/EDTA/proteinase K/1% SDS before phenol/chloroform DNA extraction as detailed in Materials and Methods. After precipitation with ethanol, 10 μg of DNA was loaded per lane and separated on a 1.2% agarose gel.
Effect of TNF-α receptor selective mutants on human neutrophil apoptosis. (A) Human neutrophils were incubated with 0.01 to 100 ng/mL of wildtype TNF-α (wtTNF-α, ▪), the TNFR55-selective mutants R32WS86T (•) or E146K (♦), and the TNFR75 selective mutant D143F (▴). Apoptosis was assessed morphologically after 3 hours. Data represent mean ± SEM of three experiments each performed in triplicate. (B) Neutrophils were incubated under identical conditions with 0 to 100 ng/mL wild-type TNF-α, 10 to 100 ng/mL E146K, or 10 to 100 ng/mL D143F. Thereafter the cells were pelletted and incubated overnight in sodium acetate/EDTA/proteinase K/1% SDS before phenol/chloroform DNA extraction as detailed in Materials and Methods. After precipitation with ethanol, 10 μg of DNA was loaded per lane and separated on a 1.2% agarose gel.
The specificity of action of TNF-α was shown in experiments where the proapoptotic effect of TNF-α was completely abolished by preincubation with mouse-antihuman TNF-α neutralizing antibody (percent apoptosis at 6 hours: control, 6.7% ± 0.6%; 25 ng/mL TNF-α, 17.3% ± 1.4%; TNF-α antibody, 6.2% ± 0.8%; TNF-α + TNF-α antibody, 6.0 ± 0.7%; n = 3). In addition, TNF-α did not affect neutrophil viability (trypan blue exclusion) or recovery rates (data not shown), excluding the possibility that the increased rates of early apoptosis observed reflected either TNF-α–induced adhesion of nonapoptotic cells33 or a TNF-α–induced switch between necrosis and apoptosis as seen in human leukemic cells treated with high concentrations of alkylating agents.34 Examination of the influence of neutrophil cell concentration on the action of TNF-α at 6 hours showed that the proapoptotic effect was most marked at 2.5 to 5 × 106 cells/mL (Fig 3). A cell concentration of 5 × 106/mL was selected for use in subsequent studies as this was the optimal cell density for preparation and quantification of cytospins. Assay of the TNF-α concentration present in cell supernatants at 0, 6, and 20 hours showed no evidence of spontaneous TNF-α production35 or decline in the level of exogenously added TNF-α (Table 1).
Time-course for TNFR55 and TNFR75 expression in the presence and absence of PAF. (A) Flow cytometric analysis of CD2 (negative control), TNFR55, and TNFR75 receptor expression in freshly isolated neutrophils. Histograms represent profiles of cell count against log fluorescence and are representative examples from nine separate experiments. (B and C) Human neutrophils (5 × 106/mL) were incubated in MDM containing 10% autologous serum in the presence or absence of PAF (1 μmol/L) for 5 minutes before incubation for 1 to 6 hours in flexiwell plates at 37°C. At these time points TNFR55 (B) and TNFR75 (C) expression was quantified by flow cytometry as detailed in Materials and Methods. Data represent percent of specific receptor expression values obtained in freshly isolated cells with each point being the mean ± SEM of three separate experiments, each performed in triplicate.
Time-course for TNFR55 and TNFR75 expression in the presence and absence of PAF. (A) Flow cytometric analysis of CD2 (negative control), TNFR55, and TNFR75 receptor expression in freshly isolated neutrophils. Histograms represent profiles of cell count against log fluorescence and are representative examples from nine separate experiments. (B and C) Human neutrophils (5 × 106/mL) were incubated in MDM containing 10% autologous serum in the presence or absence of PAF (1 μmol/L) for 5 minutes before incubation for 1 to 6 hours in flexiwell plates at 37°C. At these time points TNFR55 (B) and TNFR75 (C) expression was quantified by flow cytometry as detailed in Materials and Methods. Data represent percent of specific receptor expression values obtained in freshly isolated cells with each point being the mean ± SEM of three separate experiments, each performed in triplicate.
Relationship between TNF-α–induced apoptosis and priming.The potential physiological relevance of the proapoptotic effect of TNF-α was assessed initially by comparing the concentration-dependency of this response with the ability of TNF-α to directly stimulate superoxide anion generation in neutrophils and to prime fMLP (100 nmol/L)-stimulated respiratory burst activity. Figure 4 shows the very similar concentration-response relationships for all three effects with an EC50 for TNF-α–induced apoptosis of 2.8 ng/mL.
To assess whether the induction of apoptosis by TNF-α was itself influenced by neutrophil priming, cells were either preincubated in flexiwell plates for 6 hours or pretreated with 1 μmol/L PAF for 5 minutes before the addition of TNF-α. Priming with PAF resulted in a dramatic upregulation of fMLP-stimulated superoxide anion release (superoxide anion release, nmol/106 cells/10 min, control 0.9 ± 0.1, 100 nmol/L fMLP 3.4 ± 0.4, 1 μmol/L PAF 0.8 ± 0.1, 1 μmol/L PAF + 100 nmol/L fMLP 33.1 ± 2.0, n = 3) with the adhesion-based model also converting TNF-α into a full secretagogue agonist33 36 (and data not shown). As shown in Fig 5, both strategies abolished the proapoptotic effect of TNF-α, although by contrast, the late inhibitory effect of TNF-α on apoptosis at 20 hours appeared to be enhanced when TNF-α addition was delayed (Fig 5A). Flow cytometric analysis of TNFR55 and TNFR75 expression in freshly isolated neutrophils demonstrated a single population of TNFR55 and TNFR75 positive cells (Fig 6A) with mean fluorescence values of 4.06 ± 0.26 and 5.40 ± 0.53, respectively (CD2 control values 1.50 ± 0.10, n = 9). Incubation of neutrophils in flexiwell plates under the identical conditions described above resulted in a time-dependent decrease in both TNFR55 and TNFR75 expression (Fig 6B and C); however, preincubation of neutrophils with 1 μmol/L PAF for 5 minutes, which completely abolished the ability of TNF-α to induce apoptosis, had no effect on either TNFR55 or TNFR75 expression (Fig 6B and C).
TNFR55 and TNFR75 dependency of TNF-α–stimulated neutrophil apoptosis.The involvement of TNFR55 and TNFR75 in mediating the early proapoptotic effect of TNF-α was examined using TNF-α receptor subtype selective blocking MoAbs and agonistic mutants. In preliminary experiments the dominant role of TNFR55 in mediating TNF-α–induced priming of superoxide anion generation in neutrophils in suspension was confirmed37 38 in that the TNFR55 MoAb completely blocked TNF-α–induced priming of fMLP-stimulated superoxide anion generation whereas the TNFR75 MoAb had no effect on this response (data not shown). In contrast, however, an identical 30-minute preincubation of neutrophils with either TNFR55 or TNFR75 MoAb completely abrogated the proapoptotic effect of TNF-α (Fig 7). Neither the antibodies themselves (Fig 7) nor isotype-matched control MoAbs (data not shown) affected basal or, in the latter case, TNF-α–stimulated apoptosis. Of interest, the TNFR75 MoAb did not influence the late inhibitory effect of TNF-α on apoptosis observed at 20 hours (percent apoptosis at 20 hours: control, 58.7% ± 1.2%; TNF-α, 38.7% ± 3.4%; TNFR75 MoAb, 51.4% ± 1.6%; TNF-α + TNFR75 MoAb, 32.4% ± 1.0%). These data indicate that the TNF-α–induced priming and late inhibitory effect on apoptosis are mediated via TNFR55, but the early proapoptotic effect is dependent on both TNFR55 and TNFR75 activation.
Effect of TNFR55 and TNFR75 blocking antibodies on TNF-α–induced apoptosis in human neutrophils. Human neutrophils (5 × 106/mL) were preincubated with antihuman TNFR55 or TNFR75 MoAbs for 30 minutes at 37°C before a 6-hour incubation in the presence or absence of 12.5 ng/mL TNF-α. The extent of apoptosis was then assessed by morphological examination of cytocentrifuge preparations. Data represent mean ± SEM of three separate experiments each performed in triplicate. Where not shown, SEM values are less than 5% of means.
Effect of TNFR55 and TNFR75 blocking antibodies on TNF-α–induced apoptosis in human neutrophils. Human neutrophils (5 × 106/mL) were preincubated with antihuman TNFR55 or TNFR75 MoAbs for 30 minutes at 37°C before a 6-hour incubation in the presence or absence of 12.5 ng/mL TNF-α. The extent of apoptosis was then assessed by morphological examination of cytocentrifuge preparations. Data represent mean ± SEM of three separate experiments each performed in triplicate. Where not shown, SEM values are less than 5% of means.
Complementary experiments were performed using the TNFR55-selective TNF-α agonistic mutants E146K and R32W-S86T and the TNFR75-selective mutant D143F. The former peptides have a 3,300- and 5,000-fold lower affinity for the TNFR75 receptor with only marginal (2- and 2.2-fold) reduction in TNFR55 affinity whereas the TNFR75 ligand D143F displays a 30-fold reduced affinity to TNFR75 and no binding to TNFR55.25,26 Figure 8 shows the ability of both TNFR55 mutants to induce morphological and DNA ladder evidence of neutrophil apoptosis, albeit with a lower potency than recombinant human TNF-α (EC50 values, ng/mL: wild-type TNF-α, 5.0; E146K, 82.7; R32W-S86T, 69.5; both P < .01 compared with TNF-α). The induction of apoptosis by E146K and R32W-S86T was also inhibited completely by preincubation with TNFR55 MoAb (Fig 9). The TNFR75 selective agonist D143F, which causes a prompt induction of GM-CSF production in TNFR75 transfected PC12 cells that lack TNFR55 expression,30 did not induce apoptosis even at a concentration of 100 ng/mL (Fig 8). These data imply that TNFR75 facilitates the ability of TNFR55 to induce apoptosis in human neutrophils.
Effect of TNFR55 blocking antibodies on TNFR55-selective mutant-induced neutrophil apoptosis. Human neutrophils (5 × 106/mL) were preincubated in the presence (▨) or absence (▪) of antihuman TNFR55 MoAbs before stimulation with medium alone (control), 12.5 ng/mL TNF-α, or 100 ng/mL of the TNFR55 selective mutant proteins E146K or RWS86T for 6 hours. The extent of apoptosis was assessed morphologically. Data represent mean ± SEM of three separate experiments, each performed in triplicate.
Effect of TNFR55 blocking antibodies on TNFR55-selective mutant-induced neutrophil apoptosis. Human neutrophils (5 × 106/mL) were preincubated in the presence (▨) or absence (▪) of antihuman TNFR55 MoAbs before stimulation with medium alone (control), 12.5 ng/mL TNF-α, or 100 ng/mL of the TNFR55 selective mutant proteins E146K or RWS86T for 6 hours. The extent of apoptosis was assessed morphologically. Data represent mean ± SEM of three separate experiments, each performed in triplicate.
DISCUSSION
We have shown that TNF-α has a unique and bimodal effect on the rate of apoptosis in human neutrophils and have provided an explanation for the previous divergent reports that TNF-α either inhibits,21 has no effect on,39 or induces apoptosis in neutrophils.40 41 Our data also reveal that the early proapoptotic effect of TNF-α, in contrast to its priming effect observed in neutrophils in suspension, or indeed the apoptotic effect of TNF-α observed in nonhematopoietic cells, is critically dependent on engagement of both TNFR55 and TNFR75 receptors.
Neutrophils undergo constitutive apoptosis when aged in vitro,1-7 yet appear highly resistant to any attempt to accelerate this process using physiological agonists. Indeed, we have shown that even stimuli that are potent inducers of apoptosis in other cell types (eg, corticosteroids, elevation of intracellular Ca2+ and hypoxia) all inhibit rather than augment the rate of apoptosis in these cells.17,42,43 The only other physiological agonist reported to induce neutrophil apoptosis is IL-644; however, this effect was small, has not been confirmed by at least two other groups,40 45 and the extent of apoptosis recorded (10% compared to 15% in the presence of IL-6 at 24 hours) is very different than that reported in all other comparable studies. Hence, TNF-α appears to have the unique ability not shared by other neutrophil priming and activating agents to induce neutrophil apoptosis.
The effectiveness of the TNFR55-selective mutants E146K and R32W-S86T to induce apoptosis in human neutrophils implies that TNFR75 functions to facilitate a death signal primarily initiated via TNFR55. This conclusion is supported by experiments using rat neutrophils where induction of apoptosis occurs with human TNF-α that does not interact with the mouse TNFR75 receptor.41 Involvement of TNFR75 in TNF-α–induced death appears to be restricted to hematopoietic cells and was initially thought to reflect the ability of TNFR75 to present TNF-α to TNFR55 via a “ligand passing” effect.46 However data in PC60 T-cell hybridoma cells, where coexpression of high levels of TNFR75 in addition to low levels of TNFR55 is likewise required to observe TNF-α–stimulated apoptosis, have excluded such a mechanism.47 The involvement of TNFR75-derived intracellular signals in mediating the death effect of TNF-α is supported by the recent demonstration that TNF-α can induce T-cell receptor-induced apoptosis in p55−/− mice, indicating that under certain circumstances TNFR75 can function alone to induce apoptotic cell death,18 and similar conclusions have been reached in HeLa cells using TNFR75 selective antibodies.48 The precise mechanism whereby TNFR75 initiates apoptosis or permits TNFR55-induced death remains uncertain, not least because this receptor subtype has a relatively short cytoplasmic domain with no intrinsic kinase activity or death domain sequence (as found in TNFR55 and Fas).23 However, the discovery of a TNFR75-associated kinase that phosphorylates both TNF-α receptors provides a potential mechanism whereby TNFR75 could facilitate TNFR55 intracellularly.49
The observation that only a proportion of neutrophils undergo apoptosis in response to TNF-α is of particular interest, not least because there was no detectable decline in TNF-α levels over the 20-hour incubation period studied. There is no evidence to support heterogeneous TNF-α receptor expression in neutrophils because TNF-α stimulates uniform CD18-dependent latex bead binding in nearly 100% of neutrophils50 and flow cytometric analysis demonstrates a single population of TNFR55 and TNFR75 positive cells (Fig 6A). However, heterogeneous neutrophil responses to other stimuli such as LPS augmentation of fMLP-induced Ca2+ transients are well documented51 and other factors such as cell maturity may be important in dictating the susceptibility of individual cells to apoptosis. Our data have also shown a discrete TNFR55-mediated survival effect of TNF-α which is evident at later incubation times and is particularly obvious when the early proapoptotic effect is abolished (Fig 5A); this effect is likely to limit the extent of apoptosis occurring at earlier times. Furthermore, TNF-α induces substantial TNFR55 and TNFR75 loss under our assay conditions (S.A.D., J.M., and I.D., unpublished observations), which again may further curtail the proapoptotic effect of TNF-α.52 Such a proposal would agree with the findings of Tsuchida et al,41 who have shown a correlation in rat neutrophils between TNF-α receptor numbers and TNF-α–induced apoptosis.
The loss of the proapoptotic effect of TNF-α when cells were cultured for 6 hours before cytokine addition may well reflect the major decrease in TNFR55 and TNFR75 expression that occurs over this period (Fig 6B and C), but this mechanism does not appear to account for the similar effect observed with PAF where no change in TNFR55 or TNFR75 expression was observed. Although a previous study has reported that PAF induces a 50% decline in total TNFR expression using 125I-TNF-α binding, this effect was obtained after a 2-hour rather than a 5-minute incubation period and used PAF at a concentration of 100 μmol/L.33 However, it is possible that PAF influences receptor coupling rather than expression and/or that TNF-α is sensitive to PAF-induced protease release. TNF-α has also been shown to enhance thrombospondin-mediated phagocytosis of apoptotic neutrophils by monocyte-derived macrophages,53 suggesting a potentially synergistic or dual mechanism whereby TNF-α may enhance the removal of neutrophils from an inflamed site by accelerating apoptosis and facilitating clearance.
These data indicate that in addition to its ability to upregulate many aspects of neutrophil function,54,55 TNF-α also has the capacity, unique among other priming/activating agents, to promote neutrophil apoptosis. Although the neutrophil is a short-lived cell, it is interesting to speculate that depending on the balance of inflammatory mediators present at an inflamed site, there is clearly the potential for neutrophil function and longevity to be either upregulated or downregulated. This effect of TNF-α may explain at least in part certain in vivo findings; for example, how the administration of anti–TNF-α antibodies results in delayed resolution of the neutrophilic alveolitis induced by Legionella pneumophila,56 and why pneumococcus (one of the most potent inducers of alveolar macrophage TNF-α production57 ) causes a form of pneumonia that usually resolves with minimal residual organ damage.58 In view of recent observations that genetic variations in the TNF-α gene promotor region are associated with differences in constitutive and inducible concentrations of TNF-α and that this alters the clinical course of malaria and tuberculosis infection,59 it is also tempting to speculate that similar influences may also have a bearing on neutrophil influx and clearance at sites of inflammation. The recognition that neutrophil apoptosis can be stimulated by TNF-α and that the priming and apoptotic effects of this cytokine can be dissociated may help in the design of more rational and/or selective anti-inflammatory therapy.
ACKNOWLEDGMENT
We are grateful to D. May for secretarial assistance. The TNFR55 and TNFR75 receptor-selective TNF-α mutants E146K, R32W-S86T, and D143F were kindly provided by Prof Walter Fiers (University of Ghent, Ghent, Belgium).
Supported by The Wellcome Trust, MRC (UK) and the National Health and Medical Research Council of Australia. E.R.C. is a Wellcome Trust Senior Research Fellow in Clinical Science and A.M.C. and S.A.D. are Medical Research Council Clinical Training Fellows.
Address reprint requests to Edwin R. Chilvers, MD, PhD, Respiratory Medicine Unit, Department of Medicine (RIE), University of Edinburgh, Rayne Laboratory, Medical School, Teviot Place, Edinburgh EH8 9AG, UK.

This feature is available to Subscribers Only
Sign In or Create an Account Close Modal